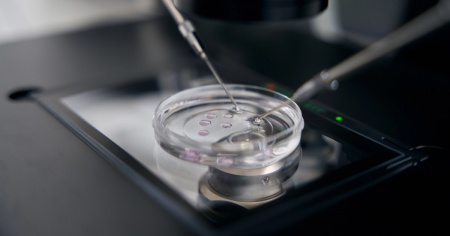

Il neonato venuto dal passato: storia di un embrione congelato nel 1994
Impiantato circa nove mesi fa nell'utero di una donna, è nato il 26 luglio scorso
WASHINGTON - Il "bambino più vecchio" del mondo è nato negli Stati Uniti il 26 luglio scorso, da un embrione congelato nel 1994. Lo riporta Sky News, citando il Mit Technology Review.
Thaddeus Daniel Pierce - questo il nome del neonato - è venuto alla luce dopo che l'embrione, congelato 31 anni fa, è stato impiantato a novembre nell'utero di Lindsey che con il compagno Tim Pierce vive in Ohio.
Come riportato da Technology Review, la madre e il padre biologici del bambino si sono sottoposti a un trattamento di fecondazione in vitro negli anni '90.
Hanno creato quattro embrioni sani, ma la madre, Linda Archerd, ne ha trasferito solo uno, che è diventata la sorella biologica di Thaddeus, oggi trentenne. Gli altri tre embrioni sono stati congelati nella speranza di poter un giorno avere un altro bambino.
"Adozione di embrioni" - Ma poi Linda e il marito si separarono e, quando lei raggiunse la menopausa, decise di rivalutare il futuro degli embrioni, decidendo di non donare gli embrioni alla scienza né di darli a una coppia anonima. Optando, invece, per l'"adozione di embrioni", che le ha permesso di avere voce in capitolo sui futuri genitori, con il processo supervisionato da un'agenzia religiosa.
Nightlight Christian Adoptions ha preso in carico gli embrioni e li ha affidati a Lindsey e Tim Pierce che corrispondevano ai criteri di Linda, ovvero una coppia cristiana caucasica sposata.




Su alcuni temi riceviamo purtroppo con frequenza messaggi contenenti insulti e incitamento all'odio e, nonostante i nostri sforzi, non riusciamo a garantire un dialogo costruttivo. Per le stesse ragioni, disattiviamo i commenti anche negli articoli dedicati a decessi, crimini, processi e incidenti.
Il confronto con i nostri lettori rimane per noi fondamentale: è una parte centrale della nostra piattaforma. Per questo ci impegniamo a mantenere aperta la discussione ogni volta che è possibile.
Dipende anche da voi: con interventi rispettosi, costruttivi e cortesi, potete contribuire a mantenere un dialogo aperto, civile e utile per tutti. Non vediamo l'ora di ritrovarvi nella prossima sezione commenti!